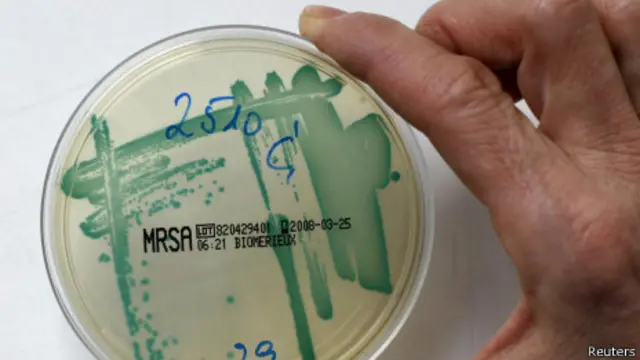
Срібло

Вчені: срібло підвищує ефективність антибіотиків
Нове дослідження свідчить, що додаючи срібло до антибіотиків, можна підвищити їхню ефективність у боротьбі з інфекціями у 10-1000 разів.
Срібло здавна відоме як протимікробний засіб, але мало знали про те, як саме воно діє.
У новому дослідженні сказано: якщо додавати срібло до існуючих антибіотиків, можна боротися зі зростанням кількості резистентних мікробів.
Команда науковців зі США виявила, експериментуючи з мишами, що срібло порушує біологічні процеси у бактерій та робить їх більш вразливими до антибіотиків.
Нині бактерії постійно адаптуються та шукають можливостей побороти антибіотики.
Як наголошує професор Дейм Селлі Девіс з Англії, антибіотики стають дедалі менш ефективними, і це викликає занепокоєння, оскільки ці зміни є незворотними.
Срібло ефективне у протидії Грам-негативним бактеріям, це один з двох головних типів бактерій, який спричиняє патології, які особливо складно лікувати.
Керував цим дослідженням Жозе-Ребун Моронес-Рамірез з медичного інституту Бостонського університету.
В інтерв'ю журналу Science Translational Medicine він заявив: "Ці результати вказують, що срібло можна використовувати для підсилення дії існуючих антибіотиків у боротьбі з Грам-негативними бактеріями".
Тепер необхідно дослідити, яким чином срібло можна додавати до ін'єкцій чи таблеток, які приймають пацієнти.




















